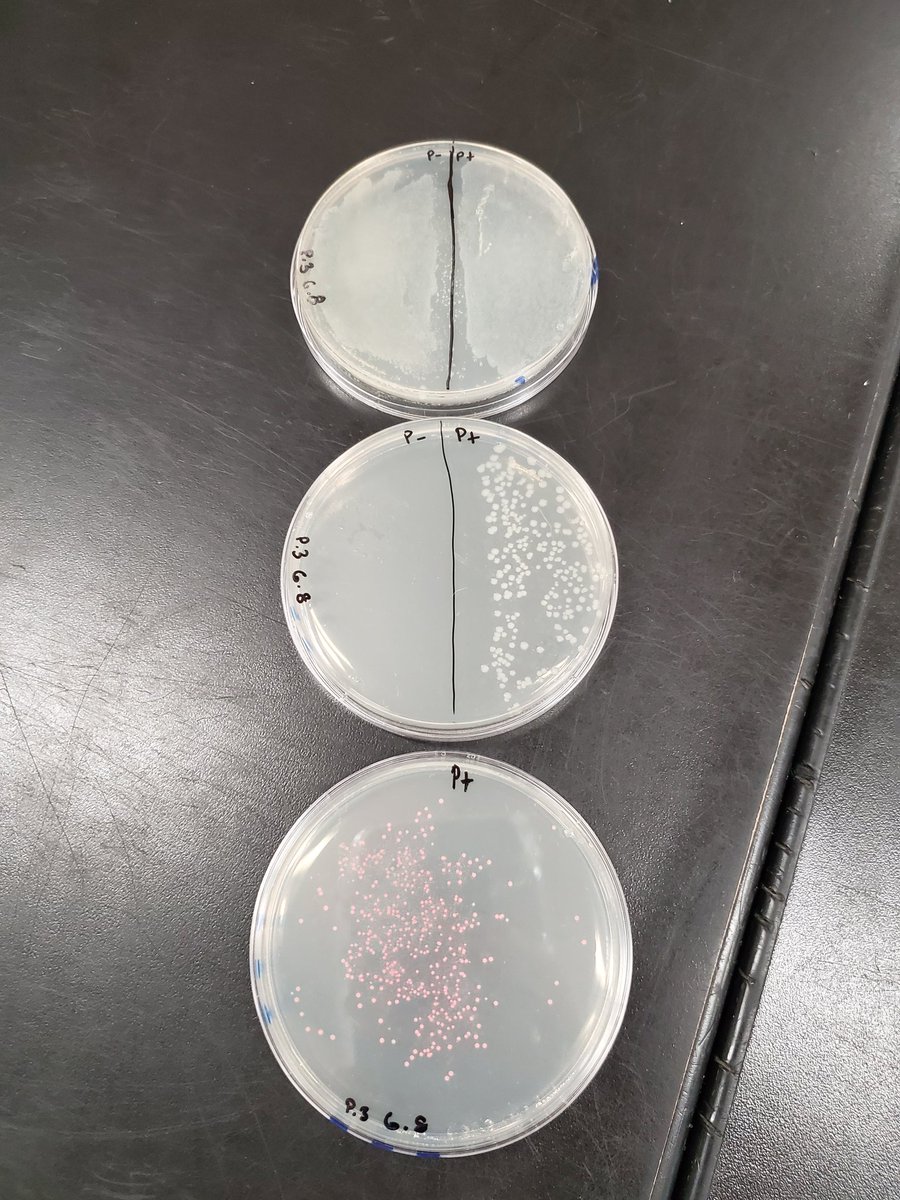
We had some awesome results with our transformed bacteria today! Students learned so much this week modeling how insulin is genetically engineered. So thankful to Amgen &amp; Miramar College for making this possible! #bringingbiotechtoec #ngss

Liz Perkoski
@perkscience
Love science and want to inspire students to love learning!
ID: 768207653361246208
23-08-2016 22:05:52
229 Tweet
139 Followers
79 Following

Students had a great time starting the ABE labs today where they are learning how to clone a gene! They are modeling the process of how insulin is produced. #bringingbiotechtoec @mrsdaniels_echs Oceanside Unified School District






Fun collaboration activity on our minimum day today!! The kids had a blast and they really had to work together on this one! #collaboration #ngss @mrsdaniels_echs Oceanside Unified School District


We were fortunate to spend the day touring Genentech today! Students got a good sense of all the different career opportunities there and saw how all the different departments work as a team to manufacture products. Eileen Frazier Oceanside Unified School District 🧬🧪


It was so great seeing my students' faces today. Did a zoom call with each period....yes, 5 hours of zoom today! Then one student sent me this text because he was so excited of the animals he got to see in Africa for the research I have them doing. #lovemyjob San Diego Zoo Safari Park


Was inspired to make this website to give my students lots of fun learning opportunities while we are apart!! Thanks @nichol_everett Mark Rauscher for the inspiration and ideas!!! #ngss @mrsdaniels_echs Eileen Frazier


In need of a little #hope right now? Teaching #STEM to the next generation gives us hope. Consider a teaching career through the EnCorps Teachers STEM Teaching Fellowship: bit.ly/33YSa0a. Apply at encorps.org/apply #inspire #ScienceMatters


I am loving using Nearpod during this Distance Learning! Nearpod Oceanside Unified School District Eileen Frazier #NearpodCertified



Excited to learn more about Pear Deck Learning #CUEBOLD




My students were so appreciative hearing from an organ recipient that has CF. Any time we can connect their learning to the real world makes such an impact! #ngss Lifesharing



Loving all these ideas Lisa Moe, M.S. EdTech